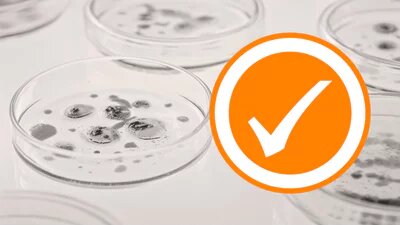

از تحریم تا خودکفایی | داروی حیاتی بیماران ریوی و سرطانی در کشور تولید شد
همشهری آنلاین – یکتا فراهانی: تحریمها دیگر نمیتوانند مانعی برای دسترسی بیماران به درمان حیاتی باشند؛ چراکه داروی نینتدانیب (اُفنیب) اکنون در کشور بومیسازی شده است. نقطه عطفی در صنعت داروسازی در شرایطی که بیماران ریوی و سرطانی برای تهیه داروهای خاص با مشکلات فراوانی دستوپنجه نرم میکنند، خبر تولید داخلی داروی «اُفنیب» نقطه عطفی